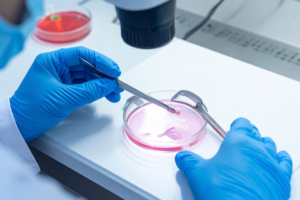

Embryo Freezing Cost: What You’ll Actually Pay From Cycle to Transfer [2026]

Most people searching for embryo freezing cost find a single number, but what they actually need is a timeline of expenses.
Embryo freezing is not just one bill. It is a series of costs that unfold over months, sometimes years, starting with your initial consultation and potentially running through a transfer long after the original egg retrieval is done.
Most people end up spending $20,000 to $32,000 from their first cycle through to their first transfer, but that number can climb if more than one cycle is needed. This complete guide gives you the full picture: upfront cycle costs, medications, storage fees, add-ons, and what the overall cost looks like when you are ready to use your embryos.
The Full Cost of Embryo Freezing at a Glance
| Cost Component | Typical Range |
|---|---|
| Clinic procedure fees | $6,000 to $11,000 |
| Fertility medications (billed separately) | $3,500 to $6,000 |
| Total per cycle (clinic + meds) | $14,000 to $20,000 |
| Annual storage fees (after year 1) | $500 to $1,000/year |
| FET procedure | $3,000 to $5,000 |
| Preimplantation genetic testing (optional) | $2,000 to $6,000 |
Two things drive the overall cost of embryo freezing:
- Upfront cycle costs: what you pay once per egg retrieval.
- Ongoing storage costs: what you pay every year until you use your embryos.
Most people plan carefully for the first and underestimate the second.
One distinction worth knowing upfront: embryo freezing costs $5,000 or more per cycle than egg-only freezing. That difference reflects the fertilization lab work required to create embryos from retrieved eggs. We cover the full comparison later in this complete guide.

Upfront Cycle Costs: What’s Typically Included
When a clinic quotes a package price, it generally covers one full egg retrieval cycle, including:
- Initial consultation and preliminary testing.
- Bloodwork and ultrasounds throughout stimulation.
- Egg retrieval procedure and anesthesia.
- Fertilization and lab work to create embryos (ICSI if needed).
- Vitrification and one year of complimentary storage.
Procedure fees alone typically run $6,000 to $11,000. That complimentary first year is worth factoring in when comparing costs across clinics.
What is almost never included? Medications.
Fertility Medications: The Cost Most Quotes Leave Out
Medications are billed separately through the pharmacy. Your clinic’s initial fee and your actual treatment cycle cost are two different numbers.
Hormonal injections are required to stimulate your ovaries to produce multiple eggs per cycle. Without them, the egg retrieval procedure cannot happen. Typical egg freezing costs for medications:
- Standard protocols: $3,500 to $6,000 per cycle.
- Complex protocols: higher, depending on your ovarian reserve and response.
Always ask whether medications are included. The vast majority of clinics bill them separately.
Patients who source medications through international pharmacies with their clinic’s guidance can cut medication costs by roughly half.
Annual Storage Fees: The Recurring Cost That Adds Up
After year one, fees to keep your embryos stored typically run $500 to $1,000 per year. Most clinics charge a flat rate regardless of how many embryos you have, meaning two embryos and ten embryos cost the same.
If you are waiting three to five years, build $1,500 to $5,000 in cumulative storage costs into your budget. The cost of freezing eggs and embryos adds up faster than most people expect.
Add-On Costs That Can Significantly Change Your Total
These are the costs that rarely appear in the headline package price.
Preimplantation Genetic Testing (PGT): Is It Worth It?
Preimplantation genetic testing (PGT-A) screens additional embryos for chromosomal abnormalities before transfer, identifying which ones are most likely to result in a healthy pregnancy.
What it costs:
- Biopsy and genetics fees: $3,000 to $6,000 per IVF cycle.
- Per-embryo fee beyond the base batch: $200 to $400.
- Two separate bills from two providers. Ask for both itemized.
Chromosomally normal embryos implant at 60 to 70%. Untested embryos implant at 30 to 40%. For patients facing multiple failed transfers at $3,000 to $5,000 each, genetic testing can reduce the overall cost substantially. The American Society for Reproductive Medicine’s 2024 guidance notes PGT-A is not established as a routine tool for all IVF patients:
- Under 35, strong ovarian reserve, no history of failed transfers: benefit is less clear.
- Over 35, history of failed transfers, or recurrent pregnancy loss: the math often shifts in favor of testing.
The FET: The Second Price Tag
When you are ready to use your embryos, the Frozen Embryo Transfer (FET) procedure adds $3,000 to $5,000, covering uterine preparation medications, monitoring appointments, embryo thaw, and the transfer itself.
Full lifecycle cost: a realistic example
| Stage | Cost Range |
|---|---|
| 1 embryo freezing cycle (including meds) | $14,000 to $20,000 |
| 3 years of storage costs | $1,500 to $3,000 |
| FET procedure | $3,000 to $5,000 |
| PGT-A (if applicable) | $2,000 to $4,000 |
| Realistic total | $20,500 to $32,000+ |
ICSI, Multiple Cycles, Mini IVF and Other Fees
ICSI (injecting a single sperm directly into each egg to maximize fertilization) adds $1,500 to $2,500. Many clinics recommend it routinely.
Multiple cycles are common. Most patients need more than one egg retrieval cycle to bank enough viable embryos. Each additional cycle restarts costs at $14,000 to $20,000. Multi-cycle packages often come at a meaningful discount. Ask before you start.
Some patients also explore mini IVF or minimal stimulation protocols, which use lower medication doses and cost less per cycle (typically $5,000 to $7,000), though they tend to retrieve fewer eggs, which can mean more cycles overall.
Other fees to clarify upfront: embryo shipping ($300 to $500+), thaw fees, and administrative and additional fees.
What Factors Determine Your Embryo Freezing Cost?
Your Age and Ovarian Reserve
Your ovarian reserve is one of the strongest predictors of total cost.
- Younger women with strong ovarian reserve tend to produce multiple eggs per cycle and need fewer cycles overall.
- Women over 35 or with diminished ovarian reserve typically need higher medication doses, may not retrieve enough eggs per cycle, and are more likely to need more than one cycle.
Before starting, your clinic will run preliminary testing: AMH, FSH, and antral follicle count. These results are the most useful data point for estimating your total cost before you begin.
Clinic Location and Expertise
Costs vary depending on clinic location and experience. A fertility clinic with pioneering research and strong outcomes may charge more per cycle but deliver better overall value by reducing how many cycles you need. Fertility clinic fees are only part of the picture. Success rates and embryology lab quality matter just as much for your family building journey.
Some patients also explore clinic networks like Kindbody, which operates multiple locations across the US with standardized pricing and published success rates, making it easier to compare costs and quality across locations.
Ask for a complete fee schedule, not just the package price. Two fertility clinics with similar quotes can differ substantially once all costs are factored in.
How Many Cycles You Need
This is the biggest variable in total cost. The average patient undergoes 2.3 to 2.7 IVF retrieval cycles in total, largely because cycles can fail for reasons outside anyone’s control, including chromosomally abnormal embryos, poor ovarian response to medications, or implantation failure. Most reproductive endocrinologists recommend banking 3 to 6 chromosomally normal embryos for a strong chance at one or more live births.
Worth asking upfront:
- Based on my preliminary testing, how many eggs are you likely to retrieve?
- How many cycles do you recommend for my age and family building goals?
- Do you offer multi-cycle packages?

Insurance Coverage for Embryo Freezing
Once you have a sense of what you might spend, the next question is how much of it you actually have to cover yourself.
The honest answer: most health insurance plans cover little or none of the embryo freezing cost, but the exceptions are meaningful enough to check carefully.
When Your Plan May Partially Cover Treatment
As of 2026, 25 states and Washington D.C. require some form of fertility insurance coverage, though what is covered by insurance varies widely depending on your state and whether your plan is fully insured or self-funded.
What coverage most commonly includes: initial consultation, ovarian reserve testing, and IVF cycles for medically diagnosed infertility in mandate states. Elective fertility preservation is covered by insurance plans far less often than medically necessary preservation.
If you are in California, there is genuinely good news. California’s Senate Bill 729 went into effect January 1, 2026, making California one of the strongest states in the country for fertility coverage. For eligible large-group plans, this includes IVF, up to three completed egg retrieval cycles, unlimited embryo transfers, and fertility treatments including medications and lab work. The law also broadens eligibility to include LGBTQ+ individuals and single parents by choice.
Key caveats:
- Self-funded employer plans are not subject to SB 729, regardless of employer size.
- Coverage kicks in at your plan’s next renewal date on or after January 1, 2026.
- Elective fertility preservation is not mandated under SB 729.
Contact your insurance provider or HR department and ask whether your health insurance plan is fully insured or self-funded, and whether IVF and embryo freezing are now covered under SB 729.
Employer Fertility Benefits: How to Find Out What You Have
Even without state-mandated coverage, your employer may offer fertility benefits. According to Carrot‘s Global Fertility at Work report, 65% of employees would change jobs for fertility benefits, and 72% would stay longer at a company that offered them. A growing number of employers in tech, finance, and healthcare now offer meaningful coverage for egg freezing treatment. This is worth checking before you assume you are covering additional costs entirely out of pocket.
How to find out:
- Ask your HR department specifically about fertility coverage, not just “reproductive health”.
- Ask whether the benefit covers fees and future transfer cycles.
- Confirm whether FSA or HSA funds apply to your egg freezing treatment.
If your employer offers benefits through Carrot, that coverage can offset a significant portion of your egg freezing costs at a fertility clinic, sometimes covering the full cost of egg retrieval, fertilization, and storage. FSA and HSA accounts let you pay for most fertility treatments with pre-tax dollars regardless of your employer plan, a real, concrete reduction in out-of-pocket cost.
How to Afford Embryo Freezing: Financing Options
There are multiple fertility financing options you should explore before committing.
Clinic Payment Plans
Most fertility clinics offer in-house payment plans with low-interest or deferred-interest options. Exploring your financial options at your initial consultation before assuming you need to pay the full cycle cost upfront. This can make a real difference in how manageable egg freezing treatment feels.
- Interest-free payment plans for 6 to 12 months
- Multi-cycle packages at a discount versus paying per cycle
- Referrals to fertility financing partners
Fertility-Specific Financing
Fertility financing platforms like Sunfish help patients access loans designed specifically for egg freezing costs, IVF, and embryo preservation. A financial advocate helps you compare rates and navigate options, reducing the additional fees that come with standard personal loans. Sunfish’s model also includes medication discounts and financial planning support to limit mid-treatment surprises.
Grants to Reduce Out-of-Pocket Costs
Several nonprofits offer fertility treatment grants worth applying for before you start:
- Baby Quest Foundation: $2,000 to $15,000, awarded twice yearly.
- Gift of Parenthood: up to $20,000 per quarter, paid directly to your clinic.
- The Tinina Q. Cade Foundation: family building grants up to $10,000.
- RESOLVE provides full grant directory at resolve.org.
Most require an application fee of $25 to $75, a medical evaluation, and financial documentation. Paying multiple years of storage costs upfront at a dedicated facility is another overlooked way to reduce your cost of freezing over time.
Egg Freezing vs. Embryo Freezing: Which Makes More Financial Sense?
| Egg Freezing | Embryo Freezing | |
|---|---|---|
| Upfront cost per egg freezing cycle | $10,000 to $15,000 | $14,000 to $20,000 |
| Fertilization included? | No (done later) | Yes |
| Thaw survival rate | 80 to 90% | Up to 99% for vitrified blastocysts |
| Quality visibility before transfer | Limited | Much higher |
| Genetic testing before transfer? | No | Yes |
| Future family flexibility | Full | Requires sperm source now |
Freezing eggs costs less upfront, but those eggs still need to go through fertilization before a transfer can happen, adding FET costs and uncertainty about how many will develop into viable embryos. Embryo freezing gives your doctor far more information before committing to a transfer, which can reduce failed IVF cycles and overall cost.
For couples, embryo freezing is generally more cost-efficient per live birth. For single women prioritizing future family flexibility, egg freezing avoids committing to a sperm source now.
One middle path: freeze eggs first, then fertilize additional embryos when you are ready. Lower initial egg freezing costs, but you will not know the quality of remaining embryos until you are ready to transfer.
Plan for the Full Journey, Not Just the First Bill
Understanding the full cost of embryo freezing before you begin is one of the most useful things you can do for yourself. Not because the numbers are scary, but because knowing them puts you in control. You will know what questions to ask, what to budget for, and which financial options apply to your situation before you are already mid-cycle.
To recap what matters most:
- A single egg freezing cycle runs $14,000 to $20,000 including medications, with annual storage fees of $500 to $1,000 per year after year one.
- A frozen embryo transfer adds $3,000 to $5,000 when you are ready to use your embryos.
- PGT is optional but often reduces total long-term costs for women over 35.
- If you are in California, SB 729 may now cover a significant portion of your treatment under qualifying large-group plans, so checking with your insurance provider and HR department before you start is essential.
- If your employer offers fertility benefits, or if you need financing options, those resources can make family building far more accessible than most people expect.
At California Center for Reproductive Health, our team walks every patient through a clear, itemized breakdown of costs before treatment begins, with no unexpected costs once you are in the middle of a cycle. Book your initial consultation today to get your personalized plan!
Eliran Mor, MD
Reproductive Endocrinologist located in Encino, Valencia & West Hollywood, CA
Reproductive Endocrinologist located in Encino, Valencia & West Hollywood, CA Doctor Mor received his medical degree from Tel Aviv University-Sackler School of Medicine in Israel. He completed a four-year residency in Obstetrics and Gynecology at New York Methodist Hospital in Brooklyn, New York. Subsequently, Dr. Mor completed a three-year fellowship in Reproductive Endocrinology and Infertility […]
Embryo Freezing Cost FAQs
Why is embryo freezing more expensive than egg freezing?
Embryo freezing includes fertilization. After egg retrieval, eggs are fertilized with sperm in the lab to create embryos before freezing, requiring additional lab work, embryologist time, and often ICSI. Those costs add $5,000 or more per egg freezing cycle compared to egg-only freezing costs.
Does storage cost more if I have more embryos?
No. Clinics typically charge a flat annual fee regardless of how many embryos you store. Two embryos and ten embryos cost the same per year, which is one reason banking more in a single cycle can be more cost-efficient.
Can I use my FSA or HSA for embryo freezing?
Yes. Most fertility treatment expenses qualify as eligible medical expenses under IRS guidelines. This covers consultations, monitoring, egg retrieval, and medications. Confirm with your plan administrator whether storage fees qualify.
What happens to my embryos if I stop paying storage fees?
Clinics typically send multiple notices before a contract lapses. If fees remain unpaid, the clinic may require a disposition decision or discard remaining embryos per your original consent agreement. Review your storage contract carefully: this is one of the unexpected costs of egg freezing that patients rarely think about upfront.
Is PGT-A worth the added cost?
For women under 35 with no history of failed transfers, the evidence is limited. For women over 35, those with recurrent pregnancy loss, or repeated failed IVF cycles, genetic testing reduces failed cycles and overall cost. Talk through your situation with your reproductive endocrinologist.
Can I move my embryos to a different clinic?
Yes. Embryo shipping typically runs $300 to $500 or more depending on distance and intake fees. You will need a release form from your current clinic before transport.
How many embryos should I freeze for one live birth?
Most reproductive endocrinologists recommend 3 to 6 chromosomally normal embryos. The right number varies depending on your age and egg freezing treatment response. Your clinic can give a personalized estimate from your preliminary testing results.
What does an FET cycle cost?
A frozen embryo transfer cycle typically costs $3,000 to $5,000, covering medications, monitoring, thaw, and the transfer. Budget for this separately from your embryo freezing cycle from day one.
Does my employer fertility benefit cover storage fees?
It varies. Ask your HR department specifically whether the benefit covers storage fees and future transfer cycles, not just the initial egg retrieval. Get the details in writing before you start treatment.
What states require insurance to cover IVF?
As of 2026, 25 states and Washington D.C. have fertility insurance mandates. These apply only to fully insured health insurance plans and not to self-insured employer plans. Confirm with your insurance provider which type of plan you have before assuming coverage applies.




